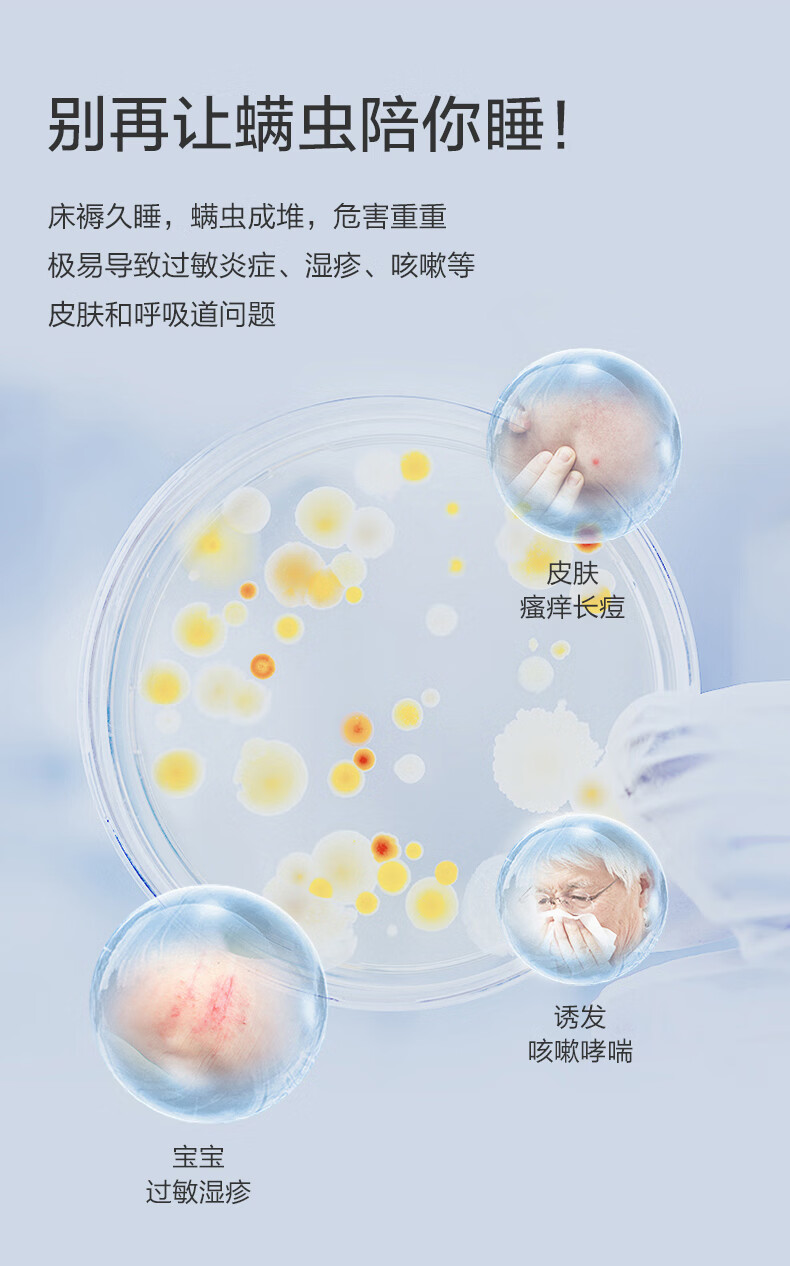

海尔(haier)除螨仪双杯尘螨分离家用床上超声波除螨虫紫外线杀菌大吸力8万次拍打HZ-C9S
¥499.00
| 运费: | 免运费 |
| 库存: | 13 件 |
商品详情

- 省哉严选 (微信公众号认证)
- 大牌!正品!低价!超省!
- 扫描二维码,访问我们的微信店铺
- 随时随地的购物、客服咨询、查询订单和物流...